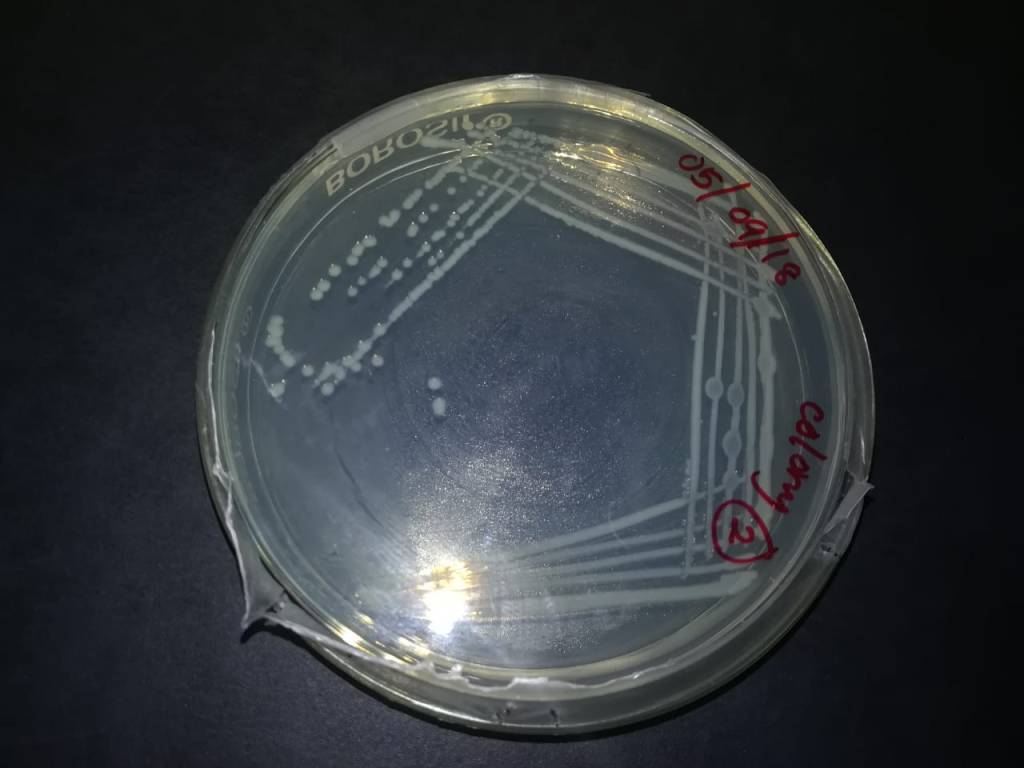

Paratransgenesis is the genetic transformation of a gut microbial symbiont of a vector to produce antipathogenic molecules. Once the transgenic microbe is reintroduced to the gut, it prevents the survival of any ingested pathogens. This review elaborates on the currently available knowledge regarding the use of this technique against leishmaniasis, emphasizing the research gaps, challenges and potential solutions.
Diverse array of microorganisms is associated with insects and they inhabit various places on and within the body of insects and in the habitat of the insects. Unlike other macro-organisms which are potential biological control agents of insect vectors, microbes are more useful as they are very easy to transform, culture and introduce to the environment. Several techniques are developed worldwide utilizing these characteristics of microorganisms to control insect vector populations. These techniques include the Sterile Insect Technique (SIT), Paratransgenesis, and entomopathogenesis based control. Among these, paratransgenesis has emerged as one of the most promising techniques in the recent past.
Our studies were focused on identifying proper bacterial candidates to be used in generating paratransgenic sand flies to control the vector mediated transmission of leishmaniasis.
Related Publications (Full papers)
Related Conference Presentations (* presenting author)
Gunathilaka P.A.D.H.N., Wijerathna A.C.T.*, Perera H.N. and Rodrigo, W.W.P. (2019). Bacterial Diversity in the Lumen of Wild Caught Leishmaniasis Vector Phlebotomus argentipes (Psychodidae: Phlebotominae. 12th International Research Conference 2019 of Kotelawala Defence University. 158pp